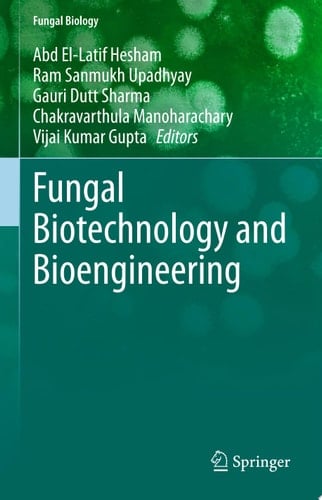
Fungal Biotechnology and Bioengineering

Fungi are eukaryotic microorganisms that include both unicellular and multicellular species. They have a worldwide distribution and a wide range of applications in diverse sectors, from environmental, food and medicine to biotechnological innovations. Fungal biochemical genetics involves the study of the relationships between genome, proteome and metabolome, and the underlying molecular processes in both native and bioengineered fungi. This book provides a valuable resource on the challenges and potential of fungal biotechnology and related bioengineering and functional diversity for various industrial applications in the food, environmental, bioenergy and biorefining, and the biopharma sectors. In comparison to previous and related publications in the area of applied myco-biotech-engineering, this book bridges a knowledge gap in the areas related to prospects and investment as well as intellectual and technical issues. This book also provides information on recent commercial and economic interests in the area by juxtaposing the developments achieved in recent worldwide research and its many challenges.
Page Count:
482
Publication Date:
2020-06-18
ISBN-10:
3030418707
ISBN-13:
9783030418700
No comments yet. Be the first to share your thoughts!